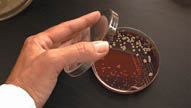

All Products
Math Mysteries Series: Crimes, Capers and Whodunits
Math Mysteries: Crimes, Capers and Whodunits is a series of five interactive mysteries designed to integrate Common Core State Standards (CCSS) in mathematics with...
View Product DetailsMath Mysteries: The Cookie Factory Mystery
In addition to the trailer above, be sure to click the "View Video" link at the bottom of this description for an informative look at how this product can be...
View Product DetailsMath Mysteries: Peterson's Last Challenge
In addition to the trailer above, be sure to click the "View Video" link at the bottom of this description for an informative look at how this product can be...
View Product DetailsMath Mysteries: Lord Symington's Castle
In addition to the trailer above, be sure to click the "View Video" link at the bottom of this description for an informative look at how this product can be...
View Product DetailsMath Mysteries: The Treasure of Pirate's Cove
In addition to the trailer above, be sure to click the "View Video" link at the bottom of this description for an informative look at how this product can be...
View Product DetailsMath Mysteries: The Clown Capers
In addition to the trailer above, be sure to click the "View Video" link at the bottom of this description for an informative look at how this product can be...
View Product DetailsSystems of the Body: Muscles and Bones
Through exciting 3-D animation plus live action video, program gives viewers a thorough introduction to the muscular-skeletal system as students see and hear how our 206...
View Product DetailsSystems of the Body: Digestion
Using 3-D animated sequences plus live-action video, program takes viewers on a tour of the digestive system from ingestion through elimination. Follow a young teen...
View Product DetailsBasic Chemistry for Biology Students
Detailed animation of chemical models introduces biology students to chemical concepts that are important to understanding life processes. Defines and illustrates...
View Product DetailsSystems of the Body: The Nervous System
Using the power of 3D animation, students enter the mysterious world of the neuron where human cells and electrical impulses work together to produce a system of...
View Product DetailsCellular Respiration: Energy for Life
How does the marathon runner keep going mile after mile? What gives a sprinter the energy for that final burst of speed? Cellular Respiration: Energy for Life takes...
View Product DetailsScientific Inquiry: Steps, Skills & Action
How do you ask the "right" question in a scientific investigation? How do you use prediction to test a potential explanation? This program helps students to appreciate...
View Product DetailsPhotosynthesis: Light into Life
This unique video and print package uses exciting color animation, on-screen diagrams, and live-action photography to enhance visual learners’ understanding of the...
View Product DetailsMeiosis: The Key to Genetic Diversity
Meiosis is a complex process that students find difficult to understand, often confusing it as a variation of mitosis. This program helps clarify the process for...
View Product DetailsPatterns of Inheritance: Understanding Genetics
Clear graphics and real-world illustrations help students sort out the complexities of Mendelian genetics. The program traces the processes and logic of Mendel’s...
View Product DetailsWord Zap: Exploring Parts of Speech
After alien Xylo crash-lands on Earth, he meets Coz, an alley cat with an excellent knowledge of the English language and its grammatical structures. Colorful animation,...
View Product DetailsWorld of Bacteria
This video uses intriguing photomicrographs to lead us into the world of bacteria. The format of the video revolves around questions: Where are bacteria found? How long...
View Product DetailsViruses: The Deadly Enemy
This video and print package helps viewers learn the basics about diseases, the immune system, evolution, and genetics. The program begins with a brief history of the...
View Product DetailsIntroduction to Cells
Video defines and illustrates a variety of animal and plant cells. A concise history of the many theories of cells is provided, from Hooke to Schleiden and Schwann. In...
View Product DetailsVocab Lab: Exploring Vocabulary with Xylo and Coz
Alien space traveler Xylo is on a mission to explore Earth and learn all he can about vocabulary. Luckily, he gets a little help from Coz, a stray cat who happens to be...
View Product DetailsRising Threat of Infectious Diseases
Program reveals how all sorts of infectious diseases such as HIV or tuberculosis and others are an increasing danger to human beings. Viewers will learn the history of...
View Product DetailsHomeostasis: The Body in Balance
This video uses a variety of vivid examples to show how homeostasis is essential for the survival of living things. Eye-catching graphics and computer animation clarify...
View Product DetailsOrganic Compounds in Action
This program is designed to help students understand the unique structures of the different organic compounds. The video uses two- and three-dimensional models as well...
View Product DetailsExploring Inheritance and Genetics
Clear graphics, live action photography, and computer animation reveal to middle school students the fascinating world of Mendelian genetics. Mendel's pea plant...
View Product DetailsWhere on the Planet Are We?
This animated adventure and extensive print package teaches children about the basic geography of planet Earth. Using engaging animation and computer graphics children...
View Product DetailsRefine Your Search
Current Search Content- Alcohol, Tobacco & Other Drugs
- Bullying & Character Education
- Guidance & Career Education
- Health, Physical Education & Sex Education
- Psychology & Emotional Health
- Core Subjects
- Elementary (K-2)
- Intermediate (3-6)
- Middle School (6-8)
- High School / College (9+)
- Parent / Professional